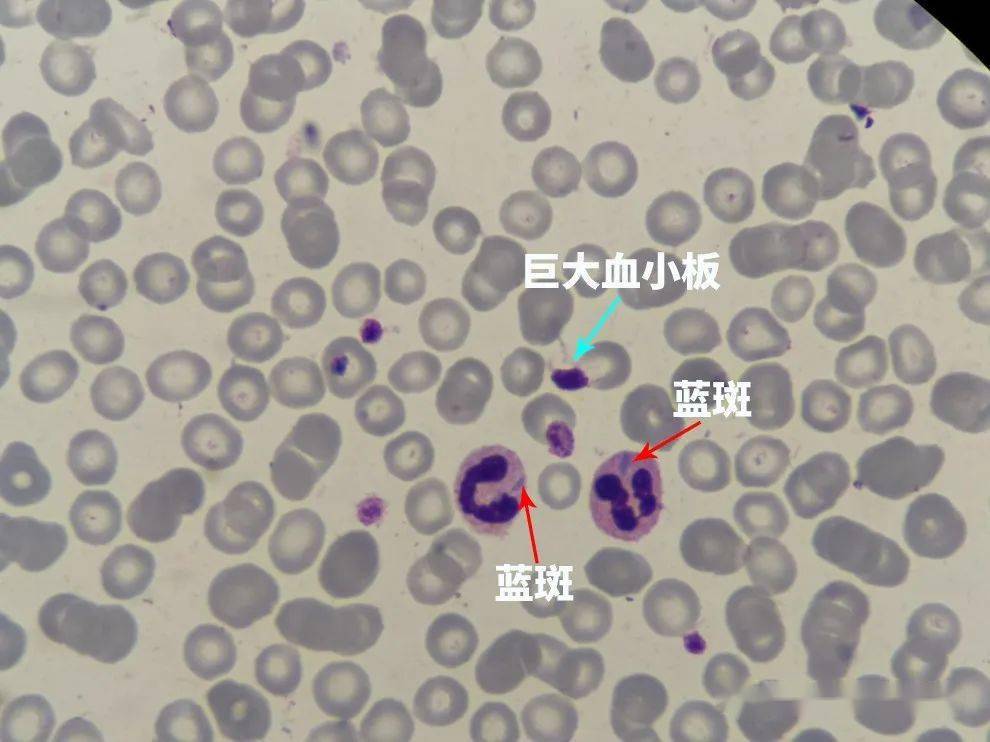
一例may-hegglin异常病例分享_血小板

畸形血小板

如杆状,逗点状,蝌蚪状,蛇形和丝形突起等不规则形改变,以及畸形血小板
图片尺寸1200x1064
畸形血小板/大血小板,巨血小板
图片尺寸640x430
答案:畸形血小板
图片尺寸1935x1709
图21 畸形血小板:长轴状,蛇形,花生,三角形等,病理情况下可见(瑞氏
图片尺寸534x530
其它 基础细胞图片 写美篇答案:畸形血小板 形态特征:呈蛇形,染紫红色
图片尺寸1156x1223
9,畸形血小板/巨大血小板
图片尺寸623x605
形态异常致血小板假性减低一例
图片尺寸800x591
终于遇见你,may-hegglin畸形!|红细胞|血小板|粒细胞|血常规_网易订阅
图片尺寸552x312
秀山医学检验质量控制中心第三十二期形态学培训答案解析
图片尺寸1200x826
终于遇见你,may-hegglin畸形!|红细胞|血小板|粒细胞|血常规_网易订阅
图片尺寸552x449
一例may-hegglin异常病例分享_血小板
图片尺寸1043x738
常见异常血小板形态
图片尺寸514x385
一例may-hegglin异常病例分享_血小板
图片尺寸990x742
一例may-hegglin异常病例分享_血小板
图片尺寸990x742
形态异常致血小板假性减低一例
图片尺寸800x553
一例may-hegglin异常病例分享_血小板
图片尺寸990x742
你以为的免疫性血小板减少症可能并不是
图片尺寸472x345
临床检验案例儿童血小板异常升高
图片尺寸640x321
p>血栓细胞,又称凝血细胞,血栓球,是哺乳动物血小板的旧称.
图片尺寸800x534
原发免疫性血小板减少症(itp),以往称特发性血小板减少性紫癜,是一种
图片尺寸640x412